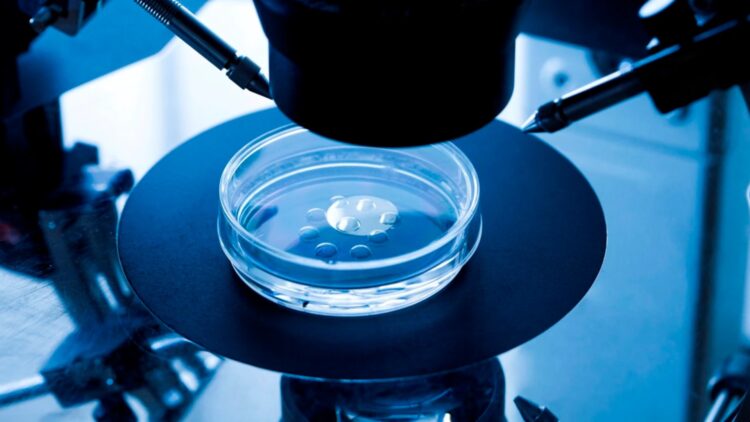

Një grua në Australi ka lindur pa e ditur fëmijën e një fëmijë të huaj, pasi klinika e saj e fertilitetit i implantoi aksidentalisht embrionet e një gruaje tjetër. Klinika “Monash IVF” 2është fajësuar nga autoritet për gabim njerëzor.
“Në emër të Monash IVF, dua të them sinqerisht më vjen shumë keq për atë që ka ndodhur,”-tha CEO Michael Knaap, duke shtuar se të gjithë në klinikën e fertilitetit ishin të shkatërruar nga gabimi. Vitin e kaluar, e njëjta klinikë pagoi një shumë prej 56 milionë dollarësh për qindra pacientë, embrionet e të cilëve u shkatërruan pavarësisht se ato ishin të zbatueshme.
Sipas një zëdhënësi të “Monash IVF”, stafi u ndërgjegjësua për problemin në shkurt, kur prindërit e kërkuan të transferonin embrionet e tyre të ngrira në një klinikë tjetër. “Monash IVF” ka konfirmuar se një embrion nga një pacient tjetër ishte shkrirë gabimisht dhe transferuar te personi i gabuar, duke rezultuar në lindjen e një fëmije. Klinika tashmë ka nisur hetimet dhe ngjarja i është referuar organeve rregullatorë.

Discussion about this post